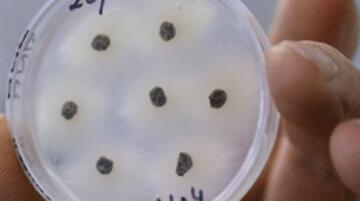

Få adgang til alt indhold på Food Supply
Ingen binding eller kortoplysninger krævet
Allerede abonnent? Log ind
Gælder kun personlig abonnement.
Kontakt os for en virksomhedsløsning.